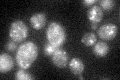
YMR171C
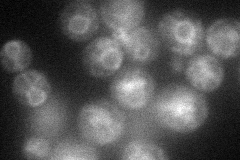
YMR171C
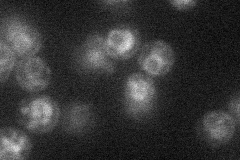
YMR171C
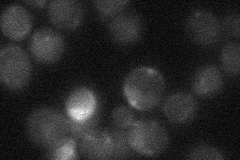
YMR171C
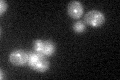
YMR171C

View description
Specificity factor required for Rsp5p-dependent ubiquitination and sorting of specific cargo proteins at the multivesicular body; mRNA is targeted to the bud via the mRNA transport system involving She2p
Localization:
Intensity:
Fold change:
Significance:
-
C’ GFP library in SD
punctate31.04 -
N' NOP1pr-GFP in SD
ER54.7118 -
N' TEF2pr-mCherry in SD
ER,vacuole19.1534 -
N' NATIVEpr-GFP in SD
below threshold22.43 -
N' TEF2pr-VC and Cyto-VN in SD

#N/A0 -
C’ GFP library in SD+DTT

punctate25.730.82No -
C’ GFP library in SD+H2O2
punctate27.730.89No -
C’ GFP library in Starvation Media

cytosol22.470.72No -
C’ GFP library on the background of Pup2-DaMP

punctate -
C’ GFP library on the background of CCT mutant

punctate33.13841.06752No
